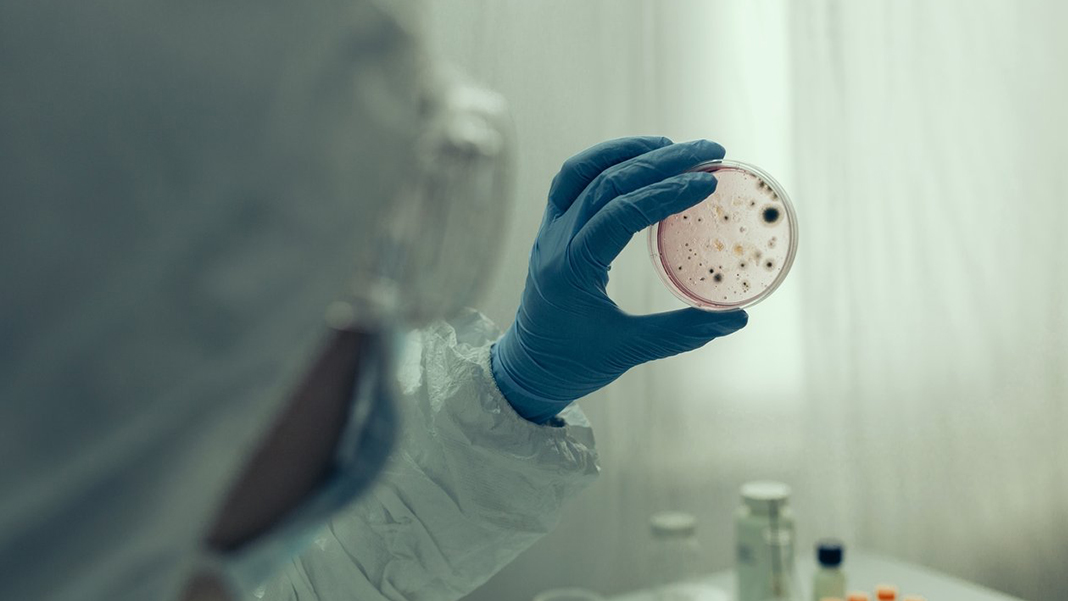
48 bin 500 yıllık virüs yeniden canlandırıldı! Hala bulaşabilir

Uluslararası ekip, bir laboratuvarda amipleri enfekte eden Sibirya'nın donmuş topraklarında ortaya çıkan toplam dokuz eski virüsü gözlemledikten sonra, bu tür virüslerin hala canlı organizmaları enfekte etme kabiliyetine sahip olduğunu ifade etti.
"İNSANLIK İÇİN SON DERECE TEHLİKELİ"
TRT Haber'de yer alan bilgilere göre bilim insanları, on binlerce senedir donmuş halde duran eski bir virüsü yeniden canlandırmasının ardından eriyen permafrostun (antik patojen) insanlık için tehlike oluşturabileceği konusunda uyarıda bulundu. Ekip, yeni keşfedilen virüslerin en eskisinin nerede ise 50 bin yaşında olduğunu açıkladı. Fransa'daki Aix-Marseille Üniversitesi'nde ekip üyesi ve aynı zamanda araştırmacı olan Jean-Michel Claverie, New Scientist'e "48 bin 500 yıl bir dünya rekoru" ifadelerini kullandı.
YEDİ ESKİ VİRÜS İNCELENDİ
Ekip, son çalışmasında toplam olarak yedi eski virüsü inceledi. Rusya, Fransa ve Almanya'dan bilim insanlarını içeren grup, daha önce 30 bin senelik diğer iki antik virüsü yeniden canlandırmayı da başarmıştı.
Ekip tarafından keşfedilen ve canlandırılan virüsler, şu ana kadar canlandırılan en eski virüsler olarak kabul edilse de, diğer bazı araştırmacılar 250 milyon senelik olduğu söylenen bakterileri yeniden canlandırdıklarını iddia ettiler.